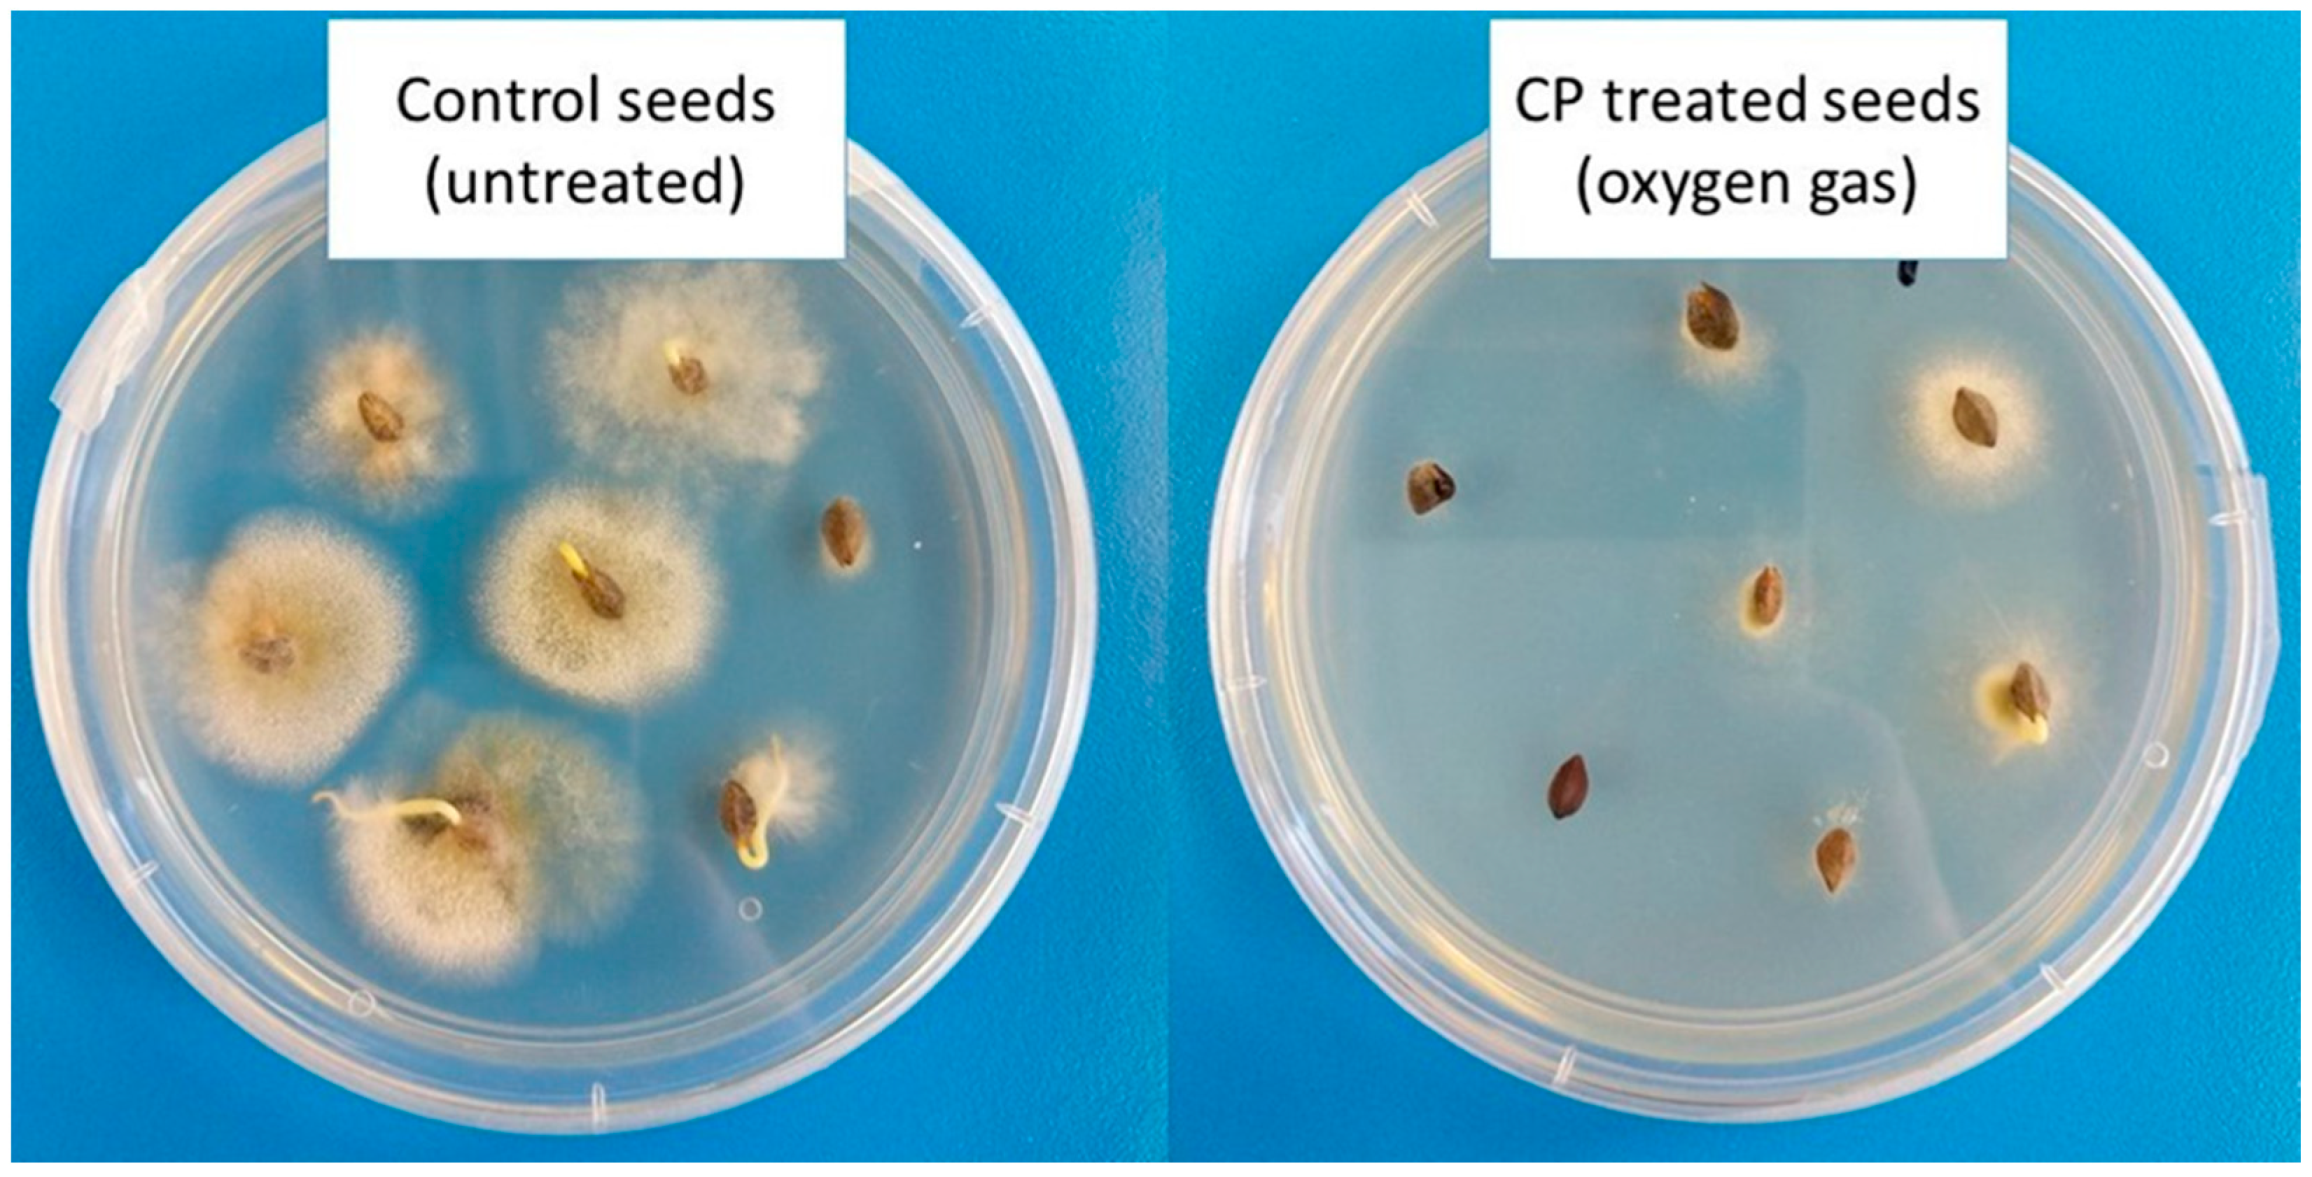
Jof 07 00650 g002

Development of Cold Plasma Technologies for Surface Decontamination of Seed Fungal Pathogens: Present Status and Perspectives
Abstract
:1. Introduction
2. The Basics of Plasma Technology
2.1. Generation of Plasma
2.1.1. Electrically Induced Plasmas
2.1.2. Radio Frequency (RF) Induced Plasmas
2.1.3. Microwave (MW) Induced Plasmas
2.2. Plasma Treatment Modes
3. Applications of Plasma Technology
3.1. Cold Plasma in Agriculture
3.2. Cold Plasma for Seed Decontamination
3.3. Molecular Mechanisms behind Microbial Decontamination
3.3.1. Effects of Reduced or Low-Pressure Plasmas (LPP)
- Inactivation of the genetic material by UV radiation: direct destruction of the genetic material of microorganisms by UV radiation (a statistical process requiring a sufficient number of DNA strand lesions).
- Intrinsic photodesorption (photon-induced desorption): In this process, UV photons break chemical bonds in microorganisms, resulting in atom-by-atom erosion of the microorganisms and the formation of intrinsic small volatile molecules (such as CO and CHx) as by-products.
- Etching: a result of the adsorption of reactive species from the plasma onto the surface of microorganisms, resulting in the formation of small volatile compounds (CO2, H2O). This mechanism can be enhanced by UV photons (“UV-induced etching”), acting synergistically with reactive species and even accelerating the elimination rate of the microorganisms. In the absence of reactive species (e.g., O-atoms), only the initial erosion process (intrinsic photodesorption) can take place, so that a much longer time is required for sterilization (Adapted from [72]).
3.3.2. Effects of Atmospheric-Pressure Plasmas (APP)
4. Conclusions & Future Research
Author Contributions
Funding
Conflicts of Interest
References
- FAO. How to Feed the World in 2050 Executive; FAO United Nations: Rome, Italy, 2009; Available online: http://www.fao.org/fileadmin/templates/wsfs/docs/expert_paper/How_to_Feed_the_World_in_2050.pdf (accessed on 28 July 2021).
- FAO. The Future of Food and Agriculture: Trends and Challenges; Annual Report 2017; FAO United Nations: Rome, Italy, 2017; ISBN 9789251095515. [Google Scholar]
- Committee, N.A.; Criteria, M. Microbiological safety evaluations and recommendations on sprouted seeds. Int. J. Food Microbiol. 1999, 52, 123–153. [Google Scholar] [CrossRef]
- Mitra, A.; Li, Y.; Klämpfl, T.G.; Shimizu, T.; Jeon, J.; Morfill, G.E.; Zimmermann, J.L. Inactivation of Surface-Borne Microorganisms and Increased Germination of Seed Specimen by Cold Atmospheric Plasma. Food Bioprocess Technol 2014, 7, 645–653. [Google Scholar] [CrossRef] [Green Version]
- Misra, N.N.; Schluter, O.; Cullen, P.J. Cold Plasma in Food and Agriculture; Academic Press: Cambridge, MA, USA, 2016; ISBN 9780128013656. [Google Scholar]
- Selcuk, M.; Oksuz, L.; Basaran, P. Decontamination of grains and legumes infected with Aspergillus spp. and Penicillum spp. by cold plasma treatment. Bioresour. Technol. 2008, 99, 5104–5109. [Google Scholar] [CrossRef]
- Iqbal, S.Z.; Asi, M.R.; Ariño, A.; Akram, N.; Zuber, M. Aflatoxin contamination in different fractions of rice from Pakistan and estimation of dietary intakes. Mycotoxin Res. 2012, 28, 175–180. [Google Scholar] [CrossRef] [PubMed]
- Iqbal, S.Z.; Asi, M.R. Assessment of aflatoxin M1 in milk and milk products from Punjab, Pakistan. Food Control 2013, 30, 235–239. [Google Scholar] [CrossRef]
- Christensen, C.M. Deterioration of Stored Grains by Fungi. Bot. Rev. 1957, 23, 108–134. [Google Scholar] [CrossRef]
- Mancini, V.; Romanazzi, G. Seed treatments to control seedborne fungal pathogens of vegetable crops. Pest Manag. Sci. 2014, 70, 860–868. [Google Scholar] [CrossRef]
- Baker, K.F. Seed Pathology—Concepts and Methods of Control. J. Seed Technol. 1979, 4, 57–67. [Google Scholar]
- Gerhardson, B. Biological substitutes for pesticides. Trends Biotechnol. 2002, 20, 338–343. [Google Scholar] [CrossRef]
- Los, A.; Ziuzina, D.; Boehm, D.; Cullen, P.J.; Bourke, P. Investigation of mechanisms involved in germination enhancement of wheat (Triticum aestivum) by cold plasma: Effects on seed surface chemistry and characteristics. Plasma Process. Polym. 2019, 16, 1–12. [Google Scholar] [CrossRef]
- Bormashenko, E.; Grynyov, R.; Bormashenko, Y.; Drori, E. Cold radiofrequency plasma treatment modifies wettability and germination speed of plant seeds. Sci. Rep. 2012, 2, 1–8. [Google Scholar] [CrossRef]
- Sadhu, S.; Thirumdas, R.; Deshmukh, R.R.; Annapure, U.S. Influence of cold plasma on the enzymatic activity in germinating mung beans (Vigna radiate). LWT-Food Sci. Technol. 2017, 78, 97–104. [Google Scholar] [CrossRef]
- Gómez-Ramírez, A.; López-Santos, C.; Cantos, M.; García, J.L.; Molina, R.; Cotrino, J.; Espinós, J.P.; González-Elipe, A.R. Surface chemistry and germination improvement of Quinoa seeds subjected to plasma activation. Sci. Rep. 2017, 7, 1–12. [Google Scholar] [CrossRef] [Green Version]
- Živković, S.; Puač, N.; Giba, Z.; Grubišić, D.; Petrović, Z.L. The stimulatory effect of non-equilibrium (low temperature) air plasma pretreatment on light-induced germination of Paulownia tomentosa seeds. Seed Sci. Technol. 2004, 32, 693–701. [Google Scholar] [CrossRef]
- Zahoranová, A.; Henselová, M.; Hudecová, D.; Kaliňáková, B.; Kováčik, D.; Medvecká, V.; Černák, M. Effect of Cold Atmospheric Pressure Plasma on the Wheat Seedlings Vigor and on the Inactivation of Microorganisms on the Seeds Surface. Plasma Chem. Plasma Process. 2016, 36, 397–414. [Google Scholar] [CrossRef]
- Ling, L.; Jiangang, L.; Minchong, S.; Chunlei, Z.; Yuanhua, D. Cold plasma treatment enhances oilseed rape seed germination under drought stress. Sci. Rep. 2015, 5, 1–10. [Google Scholar] [CrossRef]
- Park, Y.; Oh, K.S.; Oh, J.; Seok, D.C.; Kim, S.B.; Yoo, S.J.; Lee, M.J. The biological effects of surface dielectric barrier discharge on seed germination and plant growth with barley. Plasma Process. Polym. 2018, 15, 1–8. [Google Scholar] [CrossRef]
- Henselová, M.; Slováková, Ľ.; Martinka, M.; Zahoranová, A. Growth, anatomy and enzyme activity changes in maize roots induced by treatment of seeds with low-temperature plasma. Biologia 2012, 67, 490–497. [Google Scholar] [CrossRef]
- Kitazaki, S.; Koga, K.; Shiratani, M.; Hayashi, N. Growth enhancement of radish sprouts induced by low pressure o 2 radio frequency discharge plasma irradiation. Jpn. J. Appl. Phys. 2012, 51, 01AE01. [Google Scholar] [CrossRef]
- Misra, N.N.; Tiwari, B.K.; Raghavarao, K.S.M.S.; Cullen, P.J. Nonthermal Plasma Inactivation of Food-Borne Pathogens. Food Eng. Rev. 2011, 3, 159–170. [Google Scholar] [CrossRef] [Green Version]
- Misra, N.N.; Yadav, B.; Roopesh, M.S.; Jo, C. Cold Plasma for Effective Fungal and Mycotoxin Control in Foods: Mechanisms, Inactivation Effects, and Applications. Compr. Rev. Food Sci. Food Saf. 2019, 18, 106–120. [Google Scholar] [CrossRef] [Green Version]
- Pankaj, S.K.; Bueno-Ferrer, C.; Misra, N.N.; Milosavljević, V.; O’Donnell, C.P.; Bourke, P.; Keener, K.M.; Cullen, P.J. Applications of cold plasma technology in food packaging. Trends Food Sci. Technol. 2014, 35, 5–17. [Google Scholar] [CrossRef]
- Moreau, M.; Orange, N.; Feuilloley, M.G.J. Non-thermal plasma technologies: New tools for bio-decontamination. Biotechnol. Adv. 2008, 26, 610–617. [Google Scholar] [CrossRef] [PubMed]
- Misra, N.N.; Yepez, X.; Xu, L.; Keener, K. In-package cold plasma technologies. J. Food Eng. 2019, 244, 21–31. [Google Scholar] [CrossRef]
- Tendero, C.; Tixier, C.; Tristant, P.; Desmaison, J.; Leprince, P. Atmospheric pressure plasmas: A review. Spectrochim. Acta-Part B At. Spectrosc. 2006, 61, 2–30. [Google Scholar] [CrossRef]
- Piel, A. Plasma Physics: An Introduction to Laboratory, Space, and Fusion Plasmas; Springer: Berlin/Heidelberg, Germany, 2010; ISBN 9788578110796. [Google Scholar]
- Conrads, H.; Schmidt, M. Plasma generation and plasma sources. Plasma Sources Sci. Technol. 2000, 9, 441–454. [Google Scholar] [CrossRef] [Green Version]
- Wong, C.S.; Mongkolnavin, R. Elements of Plasma Technology; Springer: Singapore, 2016; ISBN 978-981-10-0115-4. [Google Scholar]
- Bogaerts, A.; Neyts, E.; Gijbels, R.; Mullen, J. Van der Gas Discharge Plasmas and Their Applications, Spectrochimica Acta Part B 57. Spectrochim. Acta Part B 2002, 57, 609–658. [Google Scholar] [CrossRef]
- Mravlje, J.; Regvar, M.; Starič, P.; Mozetič, M.; Vogel-Mikuš, K. Cold plasma affects germination and fungal community structure of buckwheat seeds. Plants 2021, 10, 851. [Google Scholar] [CrossRef]
- Laroussi, M. Low temperature plasma-based sterilization: Overview and state-of-the-art. Plasma Process. Polym. 2005, 2, 391–400. [Google Scholar] [CrossRef]
- Starič, P.; Vogel-Mikuš, K.; Mozetič, M.; Junkar, I. Effects of nonthermal plasma on morphology, genetics and physiology of seeds: A review. Plants 2020, 9, 1736. [Google Scholar] [CrossRef]
- Zhou, R.; Li, J.; Zhou, R.; Zhang, X.; Yang, S. Atmospheric-pressure plasma treated water for seed germination and seedling growth of mung bean and its sterilization effect on mung bean sprouts. Innov. Food Sci. Emerg. Technol. 2019, 53, 36–44. [Google Scholar] [CrossRef]
- Oehmigen, K.; Winter, J.; Hähnel, M.; Wilke, C.; Brandenburg, R.; Weltmann, K.D.; Von Woedtke, T. Estimation of possible mechanisms of Escherichia coli inactivation by plasma treated sodium chloride solution. Plasma Process. Polym. 2011, 8, 904–913. [Google Scholar] [CrossRef]
- Fridman, G.; Brooks, A.D.; Balasubramanian, M.; Fridman, A.; Gutsol, A.; Vasilets, V.N.; Ayan, H.; Friedman, G. Comparison of direct and indirect effects of non-thermal atmospheric-pressure plasma on bacteria. Plasma Process. Polym. 2007, 4, 370–375. [Google Scholar] [CrossRef]
- Puač, N.; Gherardi, M.; Shiratani, M. Plasma agriculture: A rapidly emerging field. Plasma Process. Polym. 2018, 15, 1–5. [Google Scholar] [CrossRef]
- Dhayal, M.; Lee, S.Y.; Park, S.U. Using low-pressure plasma for Carthamus tinctorium L. seed surface modification. Vacuum 2006, 80, 499–506. [Google Scholar] [CrossRef]
- Lynikiene, S.; Pozeliene, A.; Rutkauskas, G. Influence of corona discharge field on seed viability and dynamics of germination. Int. Agrophys. 2006, 20, 195–200. [Google Scholar]
- Šerá, B.; Šerý, M.; Viětzslav, Š.; Špatenka, P.; Tichý, M. Does cold plasma affect breaking dormancy and seed germination? A study on seeds of lamb’s quarters (Chenopodium album agg.). Plasma Sci. Technol. 2009, 11, 750–754. [Google Scholar] [CrossRef]
- Šerá, B.; Špatenka, P.; Šerý, M.; Vrchotová, N.; Hrušková, I. Influence of plasma treatment on wheat and oat germination and early growth. IEEE Trans. Plasma Sci. 2010, 38, 2963–2968. [Google Scholar] [CrossRef]
- Šera, B.; Straňák, V.; Serý, M.; Tichý, M.; Spatenka, P. Germination of chenopodium album in response to microwave plasma treatment. Plasma Sci. Technol. 2008, 10, 506–511. [Google Scholar] [CrossRef]
- Dobrin, D.; Magureanu, M.; Mandache, N.B.; Ionita, M.D. The effect of non-thermal plasma treatment on wheat germination and early growth. Innov. Food Sci. Emerg. Technol. 2015, 29, 255–260. [Google Scholar] [CrossRef]
- Iranbakhsh, A.; Ardebili, N.O.; Ardebili, Z.O.; Shafaati, M.; Ghoranneviss, M. Non-thermal Plasma Induced Expression of Heat Shock Factor A4A and Improved Wheat (Triticum aestivum L.) Growth and Resistance Against Salt Stress. Plasma Chem. Plasma Process. 2018, 38, 29–44. [Google Scholar] [CrossRef]
- Kučerová, K.; Henselová, M.; Slováková, Ľ.; Hensel, K. Effects of plasma activated water on wheat: Germination, growth parameters, photosynthetic pigments, soluble protein content, and antioxidant enzymes activity. Plasma Process. Polym. 2019, 16, 1–14. [Google Scholar] [CrossRef]
- Meng, Y.; Qu, G.; Wang, T.; Sun, Q.; Liang, D.; Hu, S. Enhancement of Germination and Seedling Growth of Wheat Seed Using Dielectric Barrier Discharge Plasma with Various Gas Sources. Plasma Chem. Plasma Process. 2017, 37, 1105–1119. [Google Scholar] [CrossRef]
- Jiang, J.; Lu, Y.; Li, J.; Li, L.; He, X.; Shao, H.; Dong, Y. Effect of seed treatment by cold plasma on the resistance of tomato to Ralstonia solanacearum (bacterial wilt). PLoS ONE 2014, 9. [Google Scholar] [CrossRef] [Green Version]
- Filatova, I.; Azharonok, V.; Lushkevich, V.; Zhukovsky, A.; Gadzhieva, G.; Spasi, K. Plasma seeds treatment as a promising technique for seed germination improvement. In Proceedings of the 31st ICPIG, Granada, Spain, 14–19 July 2013; pp. 4–7. [Google Scholar]
- Zahoranová, A.; Hoppanová, L.; Šimončicová, J.; Tučeková, Z.; Medvecká, V.; Hudecová, D.; Kaliňáková, B.; Kováčik, D.; Černák, M. Effect of Cold Atmospheric Pressure Plasma on Maize Seeds: Enhancement of Seedlings Growth and Surface Microorganisms Inactivation. Plasma Chem. Plasma Process. 2018, 38, 969–988. [Google Scholar] [CrossRef]
- Li, L.; Jiang, J.; Li, J.; Shen, M.; He, X.; Shao, H.; Dong, Y. Effects of cold plasma treatment on seed germination and seedling growth of soybean. Sci. Rep. 2014, 4, 1–7. [Google Scholar] [CrossRef] [Green Version]
- Zhang, J.J.; Jo, J.O.; Huynh, D.L.; Mongre, R.K.; Ghosh, M.; Singh, A.K.; Lee, S.B.; Mok, Y.S.; Hyuk, P.; Jeong, D.K. Growth-inducing effects of argon plasma on soybean sprouts via the regulation of demethylation levels of energy metabolism-related genes. Sci. Rep. 2017, 7, 1–12. [Google Scholar] [CrossRef] [PubMed]
- Khamsen, N.; Onwimol, D.; Teerakawanich, N.; Dechanupaprittha, S.; Kanokbannakorn, W.; Hongesombut, K.; Srisonphan, S. Rice (Oryza sativa L.) Seed Sterilization and Germination Enhancement via Atmospheric Hybrid Nonthermal Discharge Plasma. ACS Appl. Mater. Interfaces 2016, 8, 19268–19275. [Google Scholar] [CrossRef] [PubMed]
- Jiang, J.; Li, J.; Dong, Y. Effect of cold plasma treatment on seedling growth and nutrient absorption of tomato. Plasma Sci. Technol. 2018, 20. [Google Scholar] [CrossRef] [Green Version]
- Măgureanu, M.; Sîrbu, R.; Dobrin, D.; Gîdea, M. Stimulation of the Germination and Early Growth of Tomato Seeds by Non-thermal Plasma. Plasma Chem. Plasma Process. 2018, 38, 989–1001. [Google Scholar] [CrossRef]
- Meiqiang, Y.; Mingjing, H.; Buzhou, M.; Tengcai, M. Stimulating Effects of Seed Treatment by Magnetized Plasma on Tomato Growth and Yield. Plasma Sci. Technol. 2005, 7, 3143. [Google Scholar] [CrossRef]
- Sivachandiran, L.; Khacef, A. Enhanced seed germination and plant growth by atmospheric pressure cold air plasma: Combined effect of seed and water treatment. RSC Adv. 2017, 7, 1822–1832. [Google Scholar] [CrossRef] [Green Version]
- Matra, K. Non-thermal Plasma for Germination Enhancement of Radish Seeds. Procedia Comput. Sci. 2016, 86, 132–135. [Google Scholar] [CrossRef] [Green Version]
- Volin, J.C.; Denes, F.S.; Young, R.A.; Park, S.M.T. Modification of seed germination performance through cold plasma chemistry technology. Crop Sci. 2000, 40, 1706–1718. [Google Scholar] [CrossRef]
- Puligundla, P.; Kim, J.W.; Mok, C. Effect of corona discharge plasma jet treatment on decontamination and sprouting of rapeseed (Brassica napus L.) seeds. Food Control 2017, 71, 376–382. [Google Scholar] [CrossRef]
- Tounekti, T.; Mujahid, Z.U.I.; Khemira, H. Non-thermal dielectric barrier discharge (DBD) plasma affects germination of coffee and grape seeds. AIP Conf. Proc. 2018, 1976, 10–14. [Google Scholar] [CrossRef]
- Harris, D.; Pathan, A.K.; Gothkar, P.; Joshi, A.; Chivasa, W.; Nyamudeza, P. On-farm seed priming: Using participatory methods to revive and refine a key technology. Agric. Syst. 2001, 69, 151–164. [Google Scholar] [CrossRef]
- Randeniya, L.K.; De Groot, G.J.J.B. Non-Thermal Plasma Treatment of Agricultural Seeds for Stimulation of Germination, Removal of Surface Contamination and Other Benefits: A Review. Plasma Process. Polym. 2015, 12, 608–623. [Google Scholar] [CrossRef]
- Bormashenko, E. Progress in understanding wetting transitions on rough surfaces. Adv. Colloid Interface Sci. 2015, 222, 92–103. [Google Scholar] [CrossRef]
- Hayashi, N.; Ono, R.; Shiratani, M.; Yonesu, A. Antioxidative activity and growth regulation of Brassicaceae induced by oxygen radical irradiation. Jpn. J. Appl. Phys. 2015, 54, 06GD01. [Google Scholar] [CrossRef]
- Sudhakar, N.; Nagendra-Prasad, D.; Mohan, N.; Hill, B.; Gunasekaran, M.; Murugesan, K. Assessing Influence of Ozone in Tomato Seed Dormancy Alleviation. Am. J. Plant Sci. 2011, 2, 443–448. [Google Scholar] [CrossRef] [Green Version]
- Stolárik, T.; Henselová, M.; Martinka, M.; Novák, O.; Zahoranová, A.; Černák, M. Effect of Low-Temperature Plasma on the Structure of Seeds, Growth and Metabolism of Endogenous Phytohormones in Pea (Pisum sativum L.). Plasma Chem. Plasma Process. 2015, 35, 659–676. [Google Scholar] [CrossRef]
- Park, D.P.; Davis, K.; Gilani, S.; Alonzo, C.A.; Dobrynin, D.; Friedman, G.; Fridman, A.; Rabinovich, A.; Fridman, G. Reactive nitrogen species produced in water by non-equilibrium plasma increase plant growth rate and nutritional yield. Curr. Appl. Phys. 2013, 13, 1–11. [Google Scholar] [CrossRef]
- Basaran, P.; Basaran-Akgul, N.; Oksuz, L. Elimination of Aspergillus parasiticus from nut surface with low pressure cold plasma (LPCP) treatment. Food Microbiol. 2008, 25, 626–632. [Google Scholar] [CrossRef]
- Basaran, P.; Akhan, Ü. Microwave irradiation of hazelnuts for the control of aflatoxin producing Aspergillus parasiticus. Innov. Food Sci. Emerg. Technol. 2010, 11, 113–117. [Google Scholar] [CrossRef]
- Moisan, M.; Barbeau, J.; Moreau, S.; Pelletier, J.; Tabrizian, M.; Yahia, L. Low-temperature sterilization using gas plasmas: A review of the experiments and an analysis of the inactivation mechanisms. Int. J. Pharm. 2001, 226, 1–21. [Google Scholar] [CrossRef]
- Filatova, I.; Azharonok, V.; Gorodetskaya, E.; Mel, L.; Shedikova, O.; Shik, A. Plasma-radiowave stimulation of plant seeds germination and inactivation of pathogenic microorganisms. Proc. Int. Plasma Chem. Soc. 2009, 19, 627. [Google Scholar]
- Laroussi, M.; Alexeff, I.; Kang, W.L. Biological decontamination by nonthermal plasmas. IEEE Trans. Plasma Sci. 2000, 28, 184–188. [Google Scholar] [CrossRef]
- Bewley, J.D.; Black, M. SEEDS: Physiology of Development and Germination, 2nd ed.; Springer Science & Business Media: Berlin, Germany, 1994. [Google Scholar]
- Chahtane, H.; Kim, W.; Lopez-Molina, L. Primary seed dormancy: A temporally multilayered riddle waiting to be unlocked. J. Exp. Bot. 2017, 68, 857–869. [Google Scholar] [CrossRef] [PubMed]
- Hertwig, C.; Leslie, A.; Meneses, N.; Reineke, K.; Rauh, C.; Schlüter, O. Inactivation of Salmonella Enteritidis PT30 on the surface of unpeeled almonds by cold plasma. Innov. Food Sci. Emerg. Technol. 2017, 44, 242–248. [Google Scholar] [CrossRef]
- Deng, X.; Shi, J.; Kong, M.G. Physical mechanisms of inactivation of Bacillus subtilis spores using cold atmospheric plasmas. IEEE Trans. Plasma Sci. 2006, 34, 1310–1316. [Google Scholar] [CrossRef] [Green Version]
- Navarro, S.; Donahaye, J. Innovative Environmentally Friendly Technologies to Maintain Quality of Durable Agricultural Produce; Ben-Yehoshua, S., Ed.; CRC Press: Boca Raton, FL, USA, 2005; ISBN 9780203500361. [Google Scholar]
- Duan, C.X.; Wang, X.M.; Zhu, Z.D.; Wu, X.F. Testing of Seedborne Fungi in Wheat Germplasm Conserved in the National Crop Genebank of China. Agric. Sci. China 2007, 6, 682–687. [Google Scholar] [CrossRef]
- Frisvald, J.C.; Samson, R.A. Filamentous fungi in foods and feeds: Ecology, spoilage, and mycotoxin production. In Handbook of Applied Mycology; Arora, D.K., Mukerji, K.G., Marth, E.H., Eds.; Marcel Dekker: New York, NY, USA, 1991. [Google Scholar]
- Maity, J.P.; Chakraborty, A.; Saha, A.; Santra, S.C.; Chanda, S. Radiation-induced effects on some common storage edible seeds in India infested with surface microflora. Radiat. Phys. Chem. 2004, 71, 1065–1072. [Google Scholar] [CrossRef]
- Dasan, B.G.; Boyaci, I.H.; Mutlu, M. Nonthermal plasma treatment of Aspergillus spp. spores on hazelnuts in an atmospheric pressure fluidized bed plasma system: Impact of process parameters and surveillance of the residual viability of spores. J. Food Eng. 2017, 196, 139–149. [Google Scholar] [CrossRef]
- Dasan, B.G.; Mutlu, M.; Boyaci, I.H. Decontamination of Aspergillus flavus and Aspergillus parasiticus spores on hazelnuts via atmospheric pressure fluidized bed plasma reactor. Int. J. Food Microbiol. 2016, 216, 50–59. [Google Scholar] [CrossRef]
- Šerá, B.; Zahoranová, A.; Bujdáková, H.; Šerý, M. Disinfection from pine seeds contaminated with fusarium circinatum nirenberg & O’Donnell using non-thermal plasma treatment. Rom. Rep. Phys. 2019, 71, 1–12. [Google Scholar]
- Filatova, I.; Azharonok, V.; Shik, A.; Antonuk, A.; Terletskaya, N. Fungicidal Effects of Plasma and Radio-Wave Pre-treatments on Seeds of Grain Crops and Legumes. In Plasma for Bio-Decontamination, Medicine and Food Security; Springer: Dordrecht, The Netherlands, 2012; pp. 469–479. [Google Scholar]
- Kordas, L.; Pusz, W.; Czapka, T.; Kacprzyk, R. The effect of low-temperature plasma on fungus colonization of winter wheat grain and seed quality. Pol. J. Environ. Stud. 2015, 24, 433–438. [Google Scholar]
- Ambrico, P.F.; Šimek, M.; Morano, M.; De Miccolis Angelini, R.M.; Minafra, A.; Trotti, P.; Ambrico, M.; Prukner, V.; Faretra, F. Reduction of microbial contamination and improvement of germination of sweet basil (Ocimum basilicum L.) seeds via surface dielectric barrier discharge. J. Phys. D Appl. Phys. 2017, 50, 305401. [Google Scholar] [CrossRef]
- Lee, Y.; Lee, Y.Y.; Kim, Y.S.; Balaraju, K.; Mok, Y.S.; Yoo, S.J.; Jeon, Y. Enhancement of seed germination and microbial disinfection on ginseng by cold plasma treatment. J. Ginseng Res. 2020, 45, 519–526. [Google Scholar] [CrossRef]
- Caetano-Anollés, G.; Favelukes, G.; Bauer, W.D. Optimization of Surface Sterilization for Legume Seed. Crop Sci. 1990, 30, 708–712. [Google Scholar] [CrossRef]
- Charkowski, A.O.; Sarreal, C.Z.; Mandrell, R.E. Wrinkled alfalfa seeds harbor more aerobic bacteria and are more difficult to sanitize than smooth seeds. J. Food Prot. 2001, 64, 1292–1298. [Google Scholar] [CrossRef] [PubMed]
- De Geyter, N.; Morent, R. Nonthermal Plasma Sterilization of Living and Nonliving Surfaces. Annu. Rev. Biomed. Eng. 2012, 14, 255–274. [Google Scholar] [CrossRef]
- Laroussi, M. Nonthermal decontamination of biological media by atmospheric-pressure plasmas: Review, analysis, and prospects. IEEE Trans. Plasma Sci. 2002, 30, 1409–1415. [Google Scholar] [CrossRef]
- Moisan, M.; Barbeau, J.; Crevier, M.; Pelletier, J.; Philip, N.; Saoudi, B. Plasma sterilization. Methods and mechanisms *. Pure Appl. Chem. 2002, 74, 349–358. [Google Scholar] [CrossRef]
- Feichtinger, J.; Schulz, A.; Walker, M.; Schumacher, U. Sterilisation with low-pressure microwave plasmas. Surf. Coat. Technol. 2003, 174, 564–569. [Google Scholar] [CrossRef]
- Sato, T.; Miyahara, T.; Doi, A.; Ochiai, S.; Urayama, T.; Nakatani, T. Sterilization mechanism for Escherichia coli by plasma flow at atmospheric pressure. Appl. Phys. Lett. 2006, 89, 88–90. [Google Scholar] [CrossRef]
- Shimizu, T.; Steffes, B.; Pompl, R.; Jamitzky, F.; Bunk, W.; Ramrath, K.; Georgi, M.; Stolz, W.; Schmidt, H.U.; Urayama, T.; et al. Characterization of microwave plasma torch for decontamination. Plasma Process. Polym. 2008, 5, 577–582. [Google Scholar] [CrossRef]
- Trompeter, F.J.; Neff, W.J.; Franken, O.; Heise, M.; Neiger, M.; Liu, S.; Pietsch, G.J.; Saveljew, A.B. Reduction of Bacillus subtilis and Aspergillus niger spores using nonthermal atmospheric gas discharges. IEEE Trans. Plasma Sci. 2002, 30, 1416–1423. [Google Scholar] [CrossRef]
- Vicoveanu, D.; Popescu, S.; Ohtsu, Y.; Fujita, H. Competing inactivation agents for bacterial spores in radio-frequency oxygen plasmas. Plasma Process. Polym. 2008, 5, 350–358. [Google Scholar] [CrossRef]
- Philip, N.; Saoudi, B.; Crevier, M.C.; Moisan, M.; Barbeau, J.; Pelletier, J. The respective roles of UV photons and oxygen atoms in plasma sterilization at reduced gas pressure: The case of N2-O2 mixtures. IEEE Trans. Plasma Sci. 2002, 30, 1429–1436. [Google Scholar] [CrossRef]
- Eisenman, H.C.; Casadevall, A. Synthesis and assembly of fungal melanin. Appl. Microbiol. Biotechnol. 2012, 93, 931–940. [Google Scholar] [CrossRef] [Green Version]
- Fridman, A. Plasma Chemistry; Cambridge University Press: New York, NY, USA, 2008; ISBN 9780521847353. [Google Scholar]
- Deng, X.T.; Shi, J.J.; Kong, M.G. Protein destruction by a helium atmospheric pressure glow discharge: Capability and mechanisms. J. Appl. Phys. 2007, 101, 074701. [Google Scholar] [CrossRef] [Green Version]
- Edelblute, C.M.; Malik, M.A.; Heller, L.C. Surface-dependent inactivation of model microorganisms with shielded sliding plasma discharges and applied air flow. Bioelectrochemistry 2015, 103, 22–27. [Google Scholar] [CrossRef]
- Gaunt, L.F.; Beggs, C.B.; Georghiou, G.E. Bactericidal action of the reactive species produced by gas-discharge nonthermal plasma at atmospheric pressure: A review. IEEE Trans. Plasma Sci. 2006, 34, 1257–1269. [Google Scholar] [CrossRef]
- Lu, X.; Ye, T.; Cao, Y.; Sun, Z.; Xiong, Q.; Tang, Z.; Xiong, Z.; Hu, J.; Jiang, Z.; Pan, Y. The roles of the various plasma agents in the inactivation of bacteria. J. Appl. Phys. 2008, 104, 053309. [Google Scholar] [CrossRef]
- Yusupov, M.; Bogaerts, A.; Huygh, S.; Snoeckx, R.; Van Duin, A.C.T.; Neyts, E.C. Plasma-induced destruction of bacterial cell wall components: A reactive molecular dynamics simulation. J. Phys. Chem. C 2013, 117, 5993–5998. [Google Scholar] [CrossRef]
- Herrmann, H.W.; Henins, I.; Park, J.; Selwyn, G.S. Decontamination of chemical and biological warfare (CBW) agents using an atmospheric pressure plasma jet (APPJ). Phys. Plasmas 1999, 6, 2284–2289. [Google Scholar] [CrossRef] [Green Version]
- Richardson, J.P.; Dyer, F.F.; Dobbs, F.C.; Alexeff, I.; Garland, C.; Kang, W.L. On the use ofthe resistive barrier discharge to kill bacteria: Recent results. In ICOPS 2000 IEEE Conference Record-Abstracts, Proceedings of the 27th IEEE International Conference on Plasma Science, New Orleans, LA, USA, 4–7 June 2000; IEEE: Piscataway, NJ, USA, 2000. [Google Scholar]
- Kuzmichev, A.I.; Soloshenko, I.A.; Tsiolko, V.V.; Kryzhanovsky, V.I.; Bazhenov, V.Y.; Mikhnom, L.I.; Khomich, V.A. Feature of sterilization by different type of atmospheric pressure discharges. In Proceedings of the International Symposium High Pressure Low Temperature Plasma Chemistry, Greifswald, Germany; 2001; pp. 402–406. [Google Scholar]
- Laroussi, M.; Leipold, F. Evaluation of the roles of reactive species, heat, and UV radiation in the inactivation of bacterial cells by air plasmas at atmospheric pressure. Int. J. Mass Spectrom. 2004, 233, 81–86. [Google Scholar] [CrossRef]
- Hayashi, N.; Yagyu, Y.; Yonesu, A.; Shiratani, M. Sterilization characteristics of the surfaces of agricultural products using active oxygen species generated by atmospheric plasma and UV light. Jpn. J. Appl. Phys. 2014, 53, 05FR03. [Google Scholar] [CrossRef]
- Suhem, K.; Matan, N.; Nisoa, M.; Matan, N. Inhibition of Aspergillus flavus on agar media and brown rice cereal bars using cold atmospheric plasma treatment. Int. J. Food Microbiol. 2013, 161, 107–111. [Google Scholar] [CrossRef]
- Avramidis, G.; Stüwe, B.; Wascher, R.; Bellmann, M.; Wieneke, S.; von Tiedemann, A.; Viöl, W. Fungicidal effects of an atmospheric pressure gas discharge and degradation mechanisms. Surf. Coat. Technol. 2010, 205, S405–S408. [Google Scholar] [CrossRef]
- Mendis, D.A.; Rosenberg, M.; Azam, F. A note on the possible electrostatic disruption of bacteria. IEEE Trans. Plasma Sci. 2000, 28, 1304–1306. [Google Scholar] [CrossRef]
- Montie, T.C.; Kelly-Wintenberg, K.; Reece Roth, J. An overview of research using the one atmosphere uniform glow discharge plasma (OAUGDP) for sterilization of surfaces and materials. IEEE Trans. Plasma Sci. 2000, 28, 41–50. [Google Scholar] [CrossRef]
- Kang, M.H.; Hong, Y.J.; Attri, P.; Sim, G.B.; Lee, G.J.; Panngom, K.; Kwon, G.C.; Choi, E.H.; Uhm, H.S.; Park, G. Analysis of the antimicrobial effects of nonthermal plasma on fungal spores in ionic solutions. Free Radic. Biol. Med. 2014, 72, 191–199. [Google Scholar] [CrossRef]
- Lu, Q.; Liu, D.; Song, Y.; Zhou, R.; Niu, J. Inactivation of the tomato pathogen Cladosporium fulvum by an atmospheric-pressure cold plasma jet. Plasma Process. Polym. 2014, 11, 1028–1036. [Google Scholar] [CrossRef]
- Panngom, K.; Lee, S.H.; Park, D.H.; Sim, G.B.; Kim, Y.H.; Uhm, H.S.; Park, G.; Choi, E.H. Non-thermal plasma treatment diminishes fungal viability and up-regulates resistance genes in a plant host. PLoS ONE 2014, 9, e99300. [Google Scholar] [CrossRef]
- Laroussi, M.; Mendis, D.A.; Rosenberg, M. Plasma interaction with microbes. New J. Phys. 2003, 5, 41. [Google Scholar] [CrossRef]
- Lee, G.J.; Sim, G.B.; Choi, E.H.; Kwon, Y.W.; Kim, J.Y.; Jang, S.; Kim, S.H. Optical and structural properties of plasma-treated Cordyceps bassiana spores as studied by circular dichroism, absorption, and fluorescence spectroscopy. J. Appl. Phys. 2015, 117, 023303. [Google Scholar] [CrossRef]
- Chiang, M.H.; Wu, J.Y.; Li, Y.H.; Wu, J.S.; Chen, S.H.; Chang, C.L. Inactivation of E. coli and B. subtilis by a parallel-plate dielectric barrier discharge jet. Surf. Coat. Technol. 2010, 204, 3729–3737. [Google Scholar] [CrossRef]
- Korachi, M.; Gurol, C.; Aslan, N. Atmospheric plasma discharge sterilization effects on whole cell fatty acid profiles of Escherichia coli and Staphylococcus aureus. J. Electrostat. 2010, 68, 508–512. [Google Scholar] [CrossRef]
- Song, H.P.; Kim, B.; Choe, J.H.; Jung, S.; Moon, S.Y.; Choe, W.; Jo, C. Evaluation of atmospheric pressure plasma to improve the safety of sliced cheese and ham inoculated by 3-strain cocktail Listeria monocytogenes. Food Microbiol. 2009, 26, 432–436. [Google Scholar] [CrossRef] [PubMed]

| Fungal Species | Seed Type | Plasma Source and Properties | Gas Type and Exposure Time | Key Findings | % of Germination | Ref. |
|---|---|---|---|---|---|---|
| AI Aspergillus spp. and Penicillum spp. | Tomato (Lycopersicon esculentum), wheat (Triticum durum), bean (Phaseolus vulgaris), chick pea (Cicer arietinum), soybean (Glycine max) barley (Hordeum vulgare), oat (Avena sativa), rye (Secale cereal), lentil (Lens culinaris), and corn (Zea mays) | LP CP (500 mTorr); P: 300 W; F: 1 kHz; V: 20 kV | Air gas and SF6; 5–20 min | Significant reduction to below 1% of initial fungal load | No significant effect on wheat and bean seeds | [6] |
| AI Aspergillus parasiticus | Hazelnuts (Corylus avellane), peanuts (Arachis hypogaea) and pistachio nuts (Pistacia vera) | LP CP (500 mTorr); P: 300 W; F: 1 kHz; V: 20 kV | Air gas and SF6; 1–20 min | Air plasma 1-log reduction of initial load, SF6 plasma more effective with app. 5-log decrease (after 5 min TT) | NT | [70] |
| NO microbiota | Chickpea (Cicer arietinum) | AP SMD CP; SPD: 10 mW/cm2; V: 5–17 kV | Ambient air; 0.5–5 min | Significant reduction of 1–2 log of microbial contamination | Increased up to 3 min TT | [4] |
| AI Aspergillus flavus and A. parasiticus | Hazelnuts (Corylus avellane) | AP FB CP; P: 460–655 W; F: 25 kHz; V: 5–10 kV | Air gas and N2; 1–5 min | Significant reduction of app. 4-log (CFU/g) after 5 min of air gas plasma TT | NT | [83,84] |
| AI Fusarium circinatum (pine pest) | Pine (Pinus radiata) | AP DCSBD CP; F: 14 kHz; V: 10 kV | Air gas; 5–300 s | Reduction of seedborne pathogens (14–100%) | No significant effect | [85] |
| NO microbiota and AI Fusarium nivale, F. culmorum, Trichothecium roseum, A. flavus, A. clavatus | Wheat (Triticum aestivum) | AP DCSBD CP; PVD: 100 W/cm3; P: 400 W | Ambient air; 10–600 s for NO microflora; 1–300 s for AI fungi-infected seeds | Increased inhibition of microflora with increased treatment time; Total devitalization of NO filamentous fungi after 120 s TT | Increased up to 40 s TT, then decreased | [18] |
| NO microbiota and AI A. flavus, Alternaria alternata, F. culmorum | Maize (Zea mays) | AP DCSBD CP; PVD: 80 W/cm3; P: 400 W | Ambient air; 60–300 s | Total devitalization of NO bacteria after 60 s and NO fungi 180 s TT | No significant effect up to 120 s TT, then decreased | [51] |
| NO fungi (Fusarium, Alternaria, Stemphylium) | Wheat (Triticum aestivum), spring barley (Hordeum vulgare), blue lupine (Lupinus angustifolius), soy (Glycine soja), and field pea (Pisum arvense) | AP RF CC CP; PVD: 0.6 W/cm3; F: 5.28 MHz | Air gas; 2–20 min | Reduction of fungal infection; the most effective TT at 10 and 15 min | Little enhancement in blue lupine and field pea | [86] |
| NO fungal microbiota | Wheat (Triticum aestivum) | AP CP; F: 100 Hz–83 kHz; V: 8 kV | Air gas; 3–30 s | Reduction of fungal colonies on wheat grains at the optimum 10 s TT | No significant effect | [87] |
| NO microbiota | Sweet basil (Ocimum basilicum) | AP SDBD CP; SPD: 80 mW/cm2; F: 5 kHz | Humid air; 10–600 s | Significant decrease in microbial load (up to 50% in 300 s TT) | No significant effect | [88] |
| NO microbiota (molds and yeasts) | Rapeseed (Brasica napus) | AP CDPJ CP; F: 58 kHz V: 20 kV, 58 kHz | Air gas; 0.5–3 min | Reduction by 2-log units compared to initial count | Positive effect up to 1 min TT | [61] |
| NO bacteria and fungi | Ginseng (Panax ginseng) | AP DBD; F: 60 Hz; V: 120 V | Ar and Ar/O2 mixture (80:20); 10 min each day, 3 days in a row | Ar/O2 plasma mixture had better bactericidal and fungicidal effect | Positive effect in both mixtures | [89] |
| NO fungi (molds and yeasts) | Common buckwheat (Fagopyrum esculentum) and Tartary buckwheat (F. tataricum) | LP RF CP (50 Pa); P: 1400 W; F: 27.12 MHz | Pure O2 plasma; 30–120 s | Reduction of seedborne fungi to below 50% of control after 120 s | No significant effect up to 45 s TT, then decreased | [33] |
Publisher’s Note: MDPI stays neutral with regard to jurisdictional claims in published maps and institutional affiliations. |
© 2021 by the authors. Licensee MDPI, Basel, Switzerland. This article is an open access article distributed under the terms and conditions of the Creative Commons Attribution (CC BY) license (https://creativecommons.org/licenses/by/4.0/).
Share and Cite
Mravlje, J.; Regvar, M.; Vogel-Mikuš, K. Development of Cold Plasma Technologies for Surface Decontamination of Seed Fungal Pathogens: Present Status and Perspectives. J. Fungi 2021, 7, 650. https://doi.org/10.3390/jof7080650
Mravlje J, Regvar M, Vogel-Mikuš K. Development of Cold Plasma Technologies for Surface Decontamination of Seed Fungal Pathogens: Present Status and Perspectives. Journal of Fungi. 2021; 7(8):650. https://doi.org/10.3390/jof7080650
Chicago/Turabian StyleMravlje, Jure, Marjana Regvar, and Katarina Vogel-Mikuš. 2021. "Development of Cold Plasma Technologies for Surface Decontamination of Seed Fungal Pathogens: Present Status and Perspectives" Journal of Fungi 7, no. 8: 650. https://doi.org/10.3390/jof7080650
APA StyleMravlje, J., Regvar, M., & Vogel-Mikuš, K. (2021). Development of Cold Plasma Technologies for Surface Decontamination of Seed Fungal Pathogens: Present Status and Perspectives. Journal of Fungi, 7(8), 650. https://doi.org/10.3390/jof7080650
